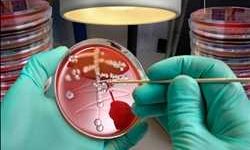

Pruebas de E coli Movimientos del mercado por análisis de tendencias, estado de crecimiento, expectativa de ingresos hasta 2028
El mercado global Pruebas de E coli extrapola las tendencias del mercado, las acciones, los ingresos y el tamaño Nuestro informe sobre investigación de mercado global de Pruebas de E …